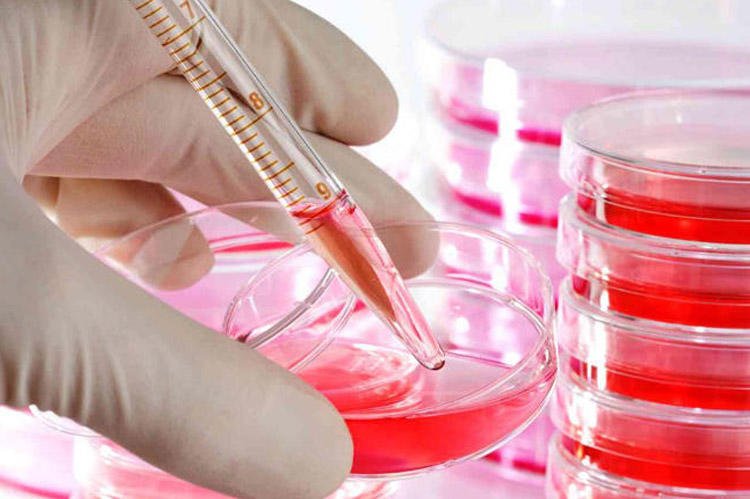

Yaponiya bu il ilk koronavirus peyvəndini istehsal edəcək
Koronavirusa qarşı Yaponiya istehsalı olan peyvənd bu il kütləvi istifadə üçün hazır ola bilər.
ARANTV.AZ Trend-ə istinadən xəbər verir ki, bu barədə Yaponiya mətbuatı bildirir.
Qeyd olunur ki, hazırda iki şirkətin hazırladığı vaksinlərin kliniki sınaqları aparılır.
Sınaqlar dekabr ayından davam edir.